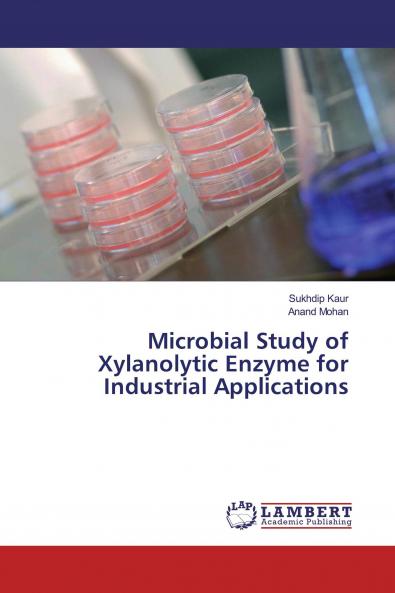
Microbial Study of Xylanolytic Enzyme for Industrial Applications

English
Paperback
₹5363
(All inclusive*)
Delivery Options
Please enter pincode to check delivery time.
*COD & Shipping Charges may apply on certain items.
Review final details at checkout.
Looking to place a bulk order? SUBMIT DETAILS
About The Book
Description
Author
This book describes the study of xylanase enzyme chielfy about the characteristics of xylanase enzyme and effect of various substrates temperature pH on xylanase activity based on the standard quantitative assays followed by an optimization of different parameters required for its industrial application primarily in bio bleaching process of industry Kraft pulp bio-pulping of wood; pulp bleaching for the production of eco-friendly products; processing food to increase clarification; treating animal feed to increase digestibility and many more.
Delivery Options
Please enter pincode to check delivery time.
*COD & Shipping Charges may apply on certain items.
Review final details at checkout.
Details
ISBN 13
9783330350427
Publication Date
-01-08-2019
Pages
-92
Weight
-131 grams
Dimensions
-150x220x5.33 mm